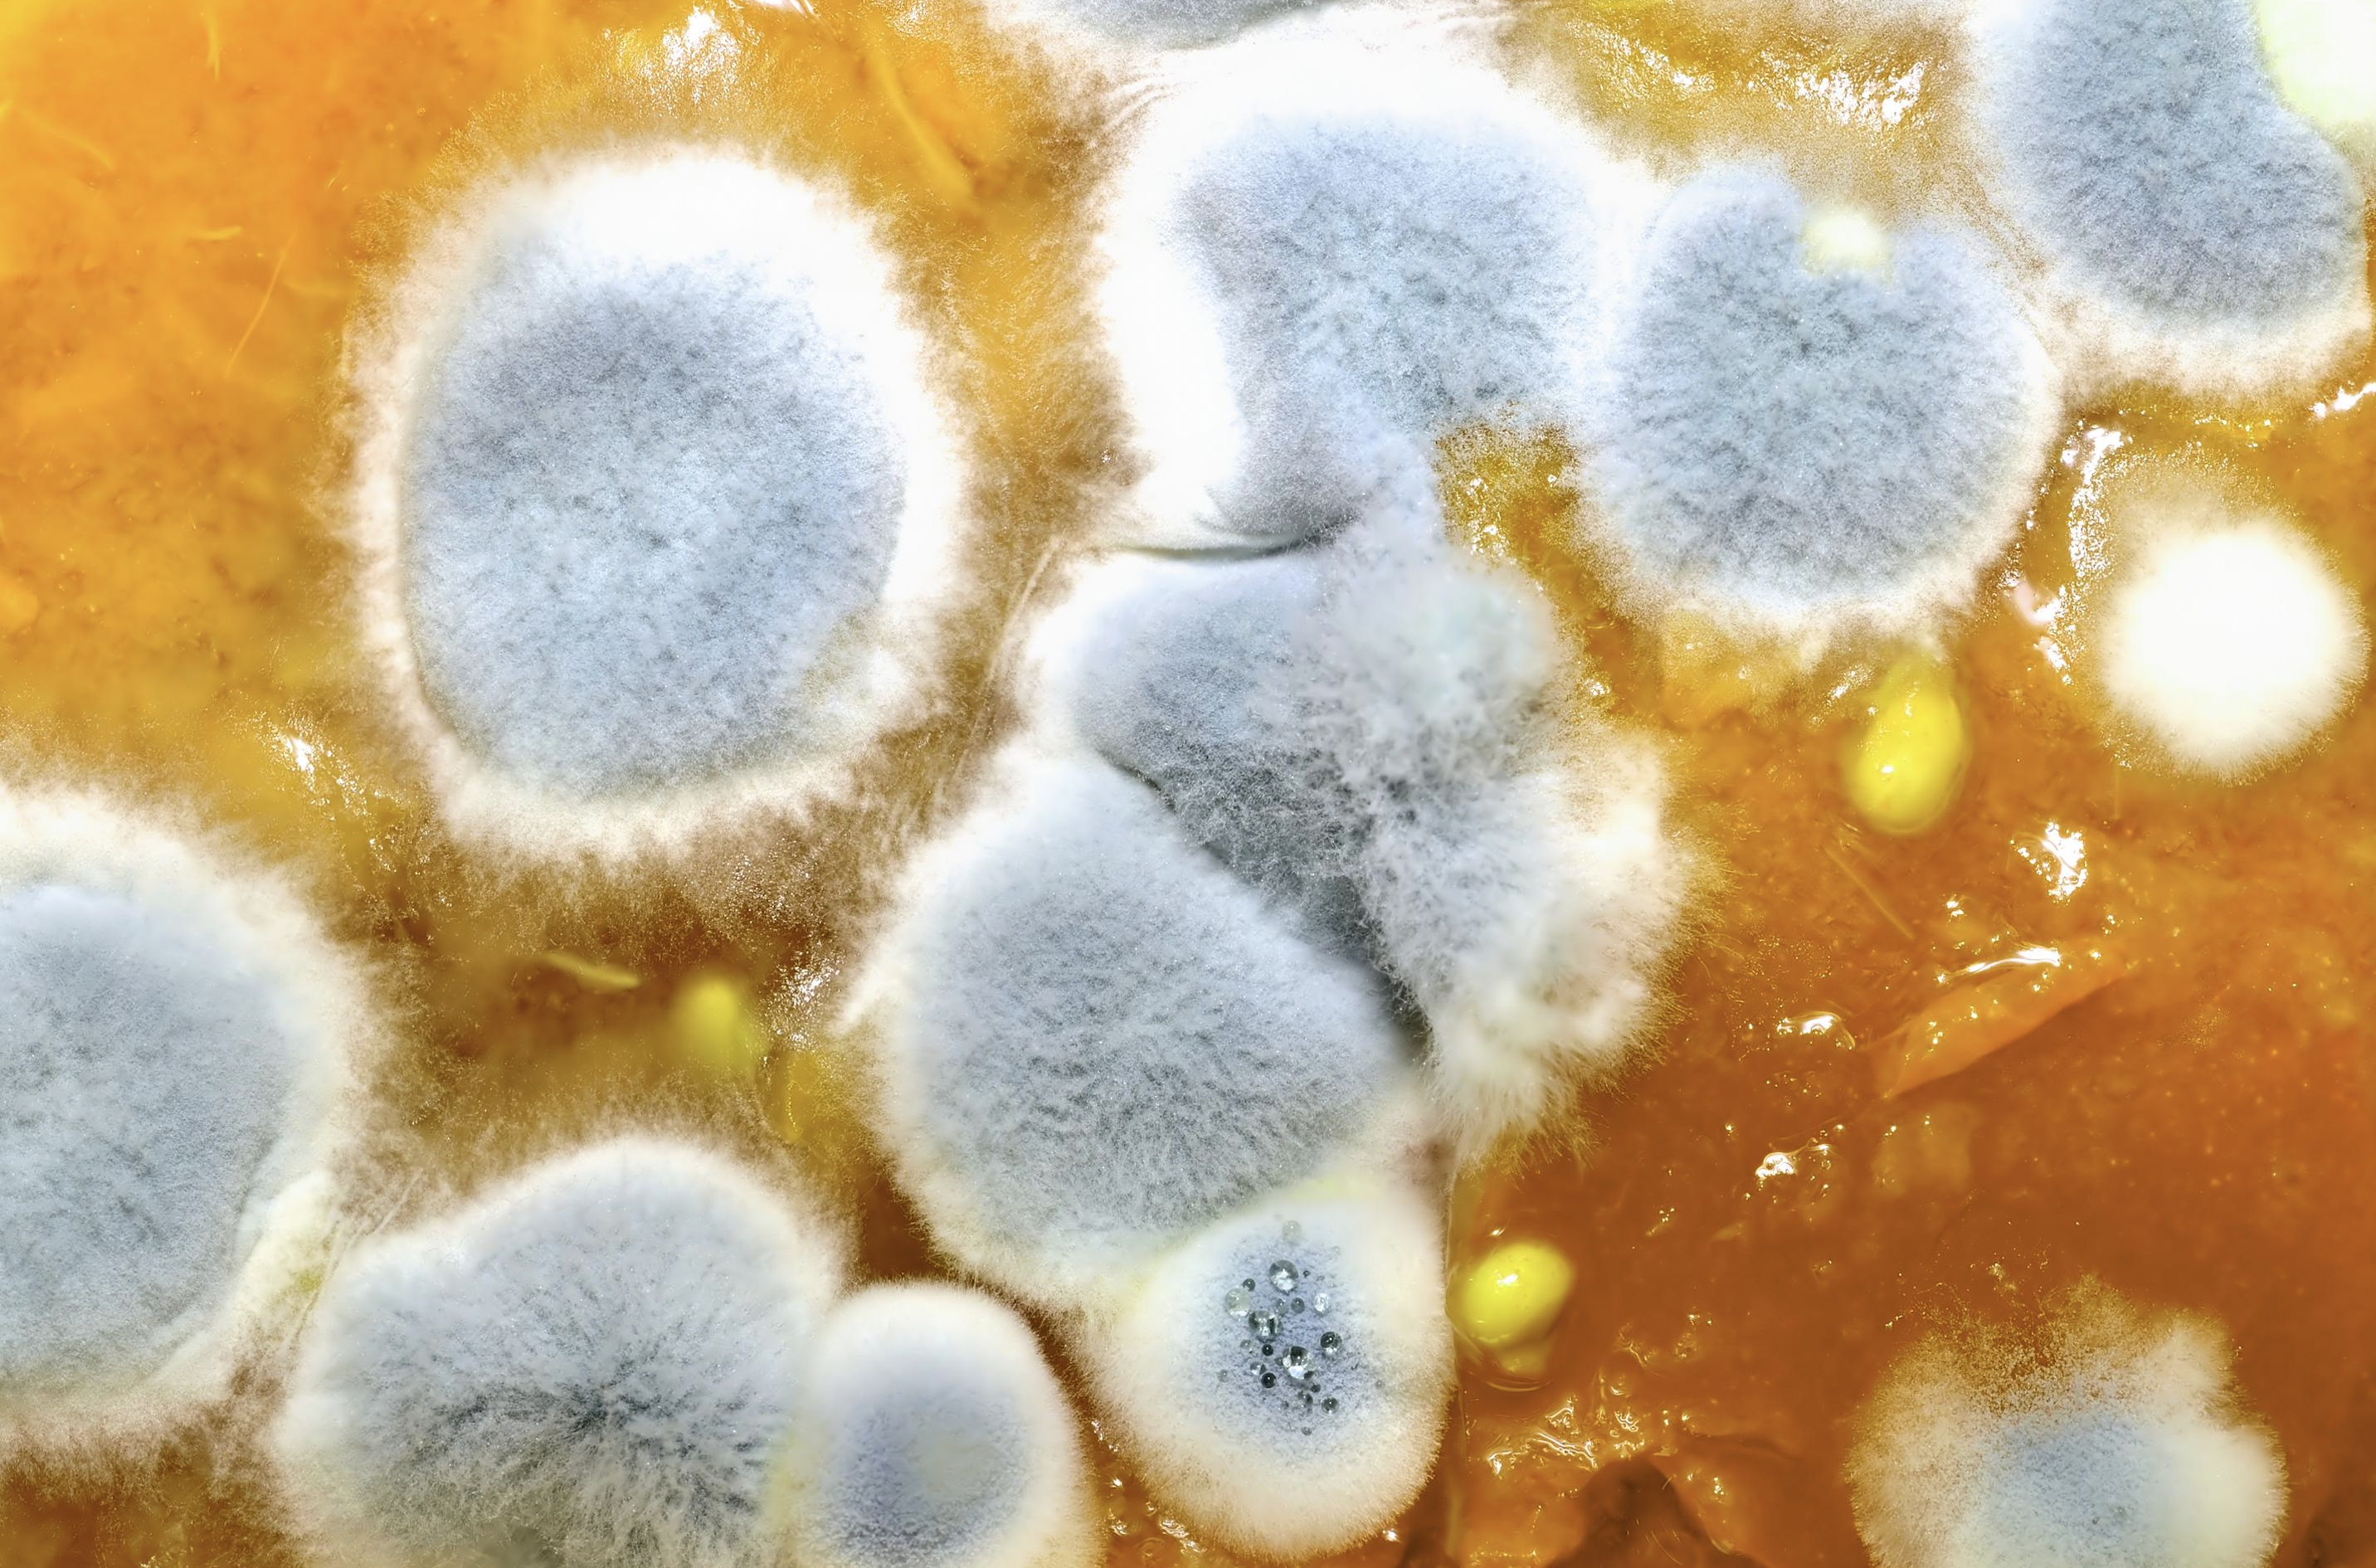

This is a common concern when people are new to fermenting foods at home, and they spot mold on their ferment.
Especially when mold can be associated with allergies and other issues.
Black mold is definitely to be avoided, and if you ever end up with a ferment that has black mold throughout, discard it.
However, what is very common to see on ferments is a white film that is mostly flat & usually forms on the top of the liquid of the ferment. Floating white spots of foam might appear as well.
Many people assume this is mold and discard the entire batch. However this mold is totally harmless and in fact is not actually mold at all.
It’s called Kahm Yeast
It is a type of yeast called kahm yeast. Even though it may look dangerous and even smell odd, it hasn’t ruined the ferment.
Kahm yeast cannot make you sick as it doesn’t contain bad bacteria
All you have to do is skim it off. Once the yeast is removed, smell and taste a small bit of the remaining ferment. If it smells and tastes fine, everything is a go. If it smells spoiled or rotten in any way, discard.
However, next time you ferment, try to eliminate the possibly of yeast by taking the following precautions:
- Peel any root vegetables first before immersing in the fermentation brine. Leaving the skin on increases the chances of yeast growth (mold too!).
- Not enough salt and/or whey was added.
- The temperature in the home is too warm (around 72 °F/ 22 °C for 2-4 days is ideal). More time is needed if the house is cooler and less if it is warmer.
- The ferment may have been exposed to too much oxygen. This can often happen if you have too much space left over in the jar.
- Ensure jars and equipment is thoroughly cleaned before fermentation.
What to do if your ferment has mold that is definitely not kahm yeast?
Fermentation mold can appear as fuzzy spots that come in all shades of colours – blue, green, black, pink, red. They typically adhere to the food that is above the liquid level inside the fermentation vessel.
If you skim off the mold and what is underneath smells ok and tastes ok, it’s safe to eat.
Much like people cut off a moldy piece of cheese and eat the remainder sans mold.
However, ultimately the choice is yours, whether to discard or keep. :)
Fermentation Kits are available to take the guess work out for you.
Head to our Amazon Store to find out which Fermentation Kit is best for you. Each kit comes with unique fermentation lids that take the worry of an unsuccessful or moldy ferment out of the equation!
After purchase you’ll also get access to The Culture Hub Club where there is ongoing support, sharing of recipes, tips and more.
Yes please, I’m ready to get started fermenting successfully!
Pssst. Follow The Raw Food Kitchen on Instagram here.